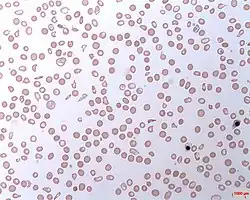

Hemoglobinúria paroxística noturna
Hemoglobinúria paroxística noturna (HPN) é uma anemia hemolítica crônica causada por um defeito na membrana das hemácias. Caracterizada pela presença de componentes das hemácias na urina (hemoglobinúria). Paroxística significa recorrente, com início e final brusco, sem aviso. O médico alemão, Paul Strübing, que a nomeou em 1881 pensou que a hemólise era causada pela acidose durante o sono[1], mas muitos anos depois se descobriu que a hemólise ocorre continuamente. Esta doença rara atinge entre 1 e 2 em cada milhão de habitantes e é igualmente prevalente em ambos os sexos.[2]
Sinais e sintomas
A forma mais clássica apresenta uma anemia hemolítica e presença dos produtos da hemólise na urina (hemoglobina e hemossiderina) faz com que ela fique com cor escura (em "cor de Coca-Cola") e às vezes o paciente apresenta icterícia (pele amarelada) e esplenomegalia (baço aumentado). A anemia é acompanhada de um sinal de regeneração moderada (reticulocitose) e de um certo grau de insuficiência medular. Os sintomas clássicos da anemia que podem estar presentes são:
- fadiga;
- falta de ar;
- palidez;
- cefaleia.
O problema maior que agrava uma evolução de um paciente com HPN é a trombose. As duas localizações mais frequentes destas tromboses são nas veias supra-hepáticas (síndrome de Budd-Chiari) e no sistema nervoso central (ACV isquêmico). Duas outras complicações são também frequentemente encontradas: as crises dolorosas abdominais (a etiologia é incerta, mas pode ser por microtrombose mesentéricas) e as infecções recorrentes (diversas viroses). As infecções são resultado da baixa no número de leucócitos (ou leucopenia). E os problemas de coagulação como hematomas, hemorragias e petéquias podem ser agravados com a baixa no número de plaquetas (ou plaquetopenia).
Muitos pacientes com anemia aplásica desenvolvem HPN. Esta anemia pode ser um resultado de um ataque do sistema imune à medula óssea, podendo ser desencadeada por uma falha no processo de hematopoese.
Fisiopatologia
No final do século XIX, Gull depois Strübing descreveram o caso de pacientes que apresentavam uma hemoglobinúria intermitente acompanhada de hemólise intravascular. Marchiafava e Nazani em 1911, depois Michelli em 1931, estabeleceram o quadro clínico clássico da doença.
A hemoglobinúria paroxística noturna (HPN), ou doença de Marchiafava & Michelli, é hoje em dia considerada como uma doença da célula-tronco hematopoiética. Desde o início dos anos 80 com o progresso da citometria de fluxo depois, mais recentemente, da biologia molecular conduziram a um avanço do conhecimento da fisiopatologia desta doença rara.
Das primeiras descrições da doença, até o início do século, a sensibilidade anormal dos glóbulos vermelhos (ou hemácias) e a ação lítica do complemento (proteínas do sistema imunitário) foram considerados como as características principais da doença.
No início dos anos 80, vários pesquisadores demonstraram que 2 proteínas inibem a ação do complemento, não estando expressas a superfície dos glóbulos vermelhos dos pacientes com HPN. Estas 2 moléculas são a DAF (decay accelerating factor) ou CD55 e a MIRL (membrane inhibitor of reactive lysis) ou CD59.
Em seguida aos trabalhos que mostraram a deficiência da expressão do CD55 e do CD59, outras deficiências moleculares foram identificadas em pacientes com HPN. Todas estas moléculas tem um elemento estrutural comum : eles são ligados à membrana por uma glicosilfosfatidilinositol (GPI).
Mesmo que as proteínas sejam expressas fisiologicamente à membrana das células sanguíneas, são normalmente sintetizadas, eles não são expressas na HPN pelo defeito da síntese do sistema de ligação à GPI.
Recentemente, uma etapa fundamental na compreensão da doença foi descoberta graças ao grupo do Dr. Kinoshita que demonstrou que a HPN estava ligada a anomalias de um gene chamado PIG-A. O gene PIG-A fica situado no cromossomo X.
Estas descobertas fundamentais abriram uma série de estudos moleculares da HPN. Várias equipes demonstraram que as alterações moleculares do gene PIG-A estão presentes entre todos os pacientes de HPN.
Diagnóstico
- Testes não específicos:
- Hemograma: presença de uma anemia microcítica. O paciente pode apresentar pancitopenia ou seja baixa na três linhas celulares, isto é, além de uma baixa quantidade de glóbulos vermelhos, o paciente apresenta baixa na quantidade de glóbulos brancos ou leucócitos (leucopenia) e no número de plaquetas (plaquetopenia).
- Reticulócitos: aumentado pela presença de hemólise.
- Hemoglobina, bilirrubina total e livre, HDL aumentadas em caso de hemólise.
- Haptoglobina: baixa ou ausente.
- Testes específicos:
- Teste de Ham: hemólise provocada em meio ácido. Quando o teste for positivo indica HPN positivo.
- Teste da Sacarose
- Citometria de fluxo: Ausência ou redução da CD59 e CD55.
- Testes de diferenciação em relação a outras doenças:
- Eletroforese de Hemoglobina: para descartar hemoglobinopatias.
- Teste de G6PD: para descartar deficiência de G6PD.
- Teste de Coombs direto: para descartar doenças autoimunes.
Tratamento
Transfusão de sangue inteiro pode ser necessária para corrigir a anemia, além de suprimir a produção de células HPN pela medula óssea e, indiretamente, reduzir a gravidade da hemólise. A deficiência de ferro se desenvolve com o tempo, devido a perdas na urina e pode ter que ser tratada com dieta e suplementos como sulfato ferroso. Suplementos de ferro por via intravenosa pode resultar em mais hemólise à medida que mais células PNH são produzidas. As evidências que corticosteroides são úteis são contraditórias.[2]
HPN é uma doença crônica portanto exige longo monitoramento. Em pacientes com poucos sintomas e poucos clones, basta um monitoramento da citometria de fluxo a cada seis meses para fornecer informações sobre a evolução e prevenir complicações potenciais. Dado o elevado risco de trombose, o tratamento preventivo com a anticoagulantes (como warfarina) é recomendado naqueles com muitos clones anormais (50% dos glóbulos brancos do tipo III). Casos de trombose são tratados como seriam em outros pacientes.[3]
O eculizumab é um anticorpo monoclonal que melhora a qualidade de vida e diminui a necessidade de transfusões de sangue, mas é um dos fármacos mais caros do mundo (US$ 440.000 por pessoa por ano). E causa um elevado risco de meningite meningocócica invasiva mesmo com vacina.[4]
Prognóstico
Sem tratamento, a sobrevida após o aparecimento dos sintomas era de cerca de 10 a 20 anos dependendo da gravidade. A morte frequentemente é por trombose causando infarto do miocárdio, tromboembolismo pulmonar ou AVC isquêmico.[5] É comum estar associada a outras doenças graves do sangue como anemia aplásica, leucemia e síndrome mielodisplásica. A gravidez é de alto risco para feto e para a mãe por aumentar o risco de transtornos da coagulação (mortalidade materna de 20%).[2]
Personalidades diagnosticadas com o HPN
No Brasil, o futebolista Alex Alves faleceu, em 2012, em decorrência da hemoglobinúria paroxística noturna.[6]
Ligações externas
Referências
- ↑ Strübing P (1882). "Paroxysmale Hämoglobinurie". Dtsch Med Wochenschr (in German). 8: 1–3 and 17–21. doi:10.1055/s-0029-1196307.
- 1 2 3 Parker C, Omine M, Richards S, et al. (2005). "Diagnosis and management of paroxysmal nocturnal hemoglobinuria". Blood. 106 (12): 3699–709. doi:10.1182/blood-2005-04-1717. PMC 1895106. PMID 16051736.
- ↑ Hall C, Richards S, Hillmen P (November 2003). "Primary prophylaxis with warfarin prevents thrombosis in paroxysmal nocturnal hemoglobinuria (PNH)". Blood. 102 (10): 3587–91. doi:10.1182/blood-2003-01-0009. PMID 12893760.
- ↑ "Patients Receiving Eculizumab (Soliris) at High Risk for Invasive Meningococcal Disease Despite Vaccination". Centers for Disease Control and Prevention Health Alert Network. 7 July 2017.
- ↑ Pu, JJ; Brodsky, RA (June 2011). "Paroxysmal nocturnal hemoglobinuria from bench to bedside". Clinical and Translational Science. 4 (3): 219–24. doi:10.1111/j.1752-8062.2011.00262.x. PMC 3128433. PMID 21707954.
- ↑ As mortes de 2012 no esporte Portal de Notícias Brasil On-Line - acessado em 7 de janeiro de 2013